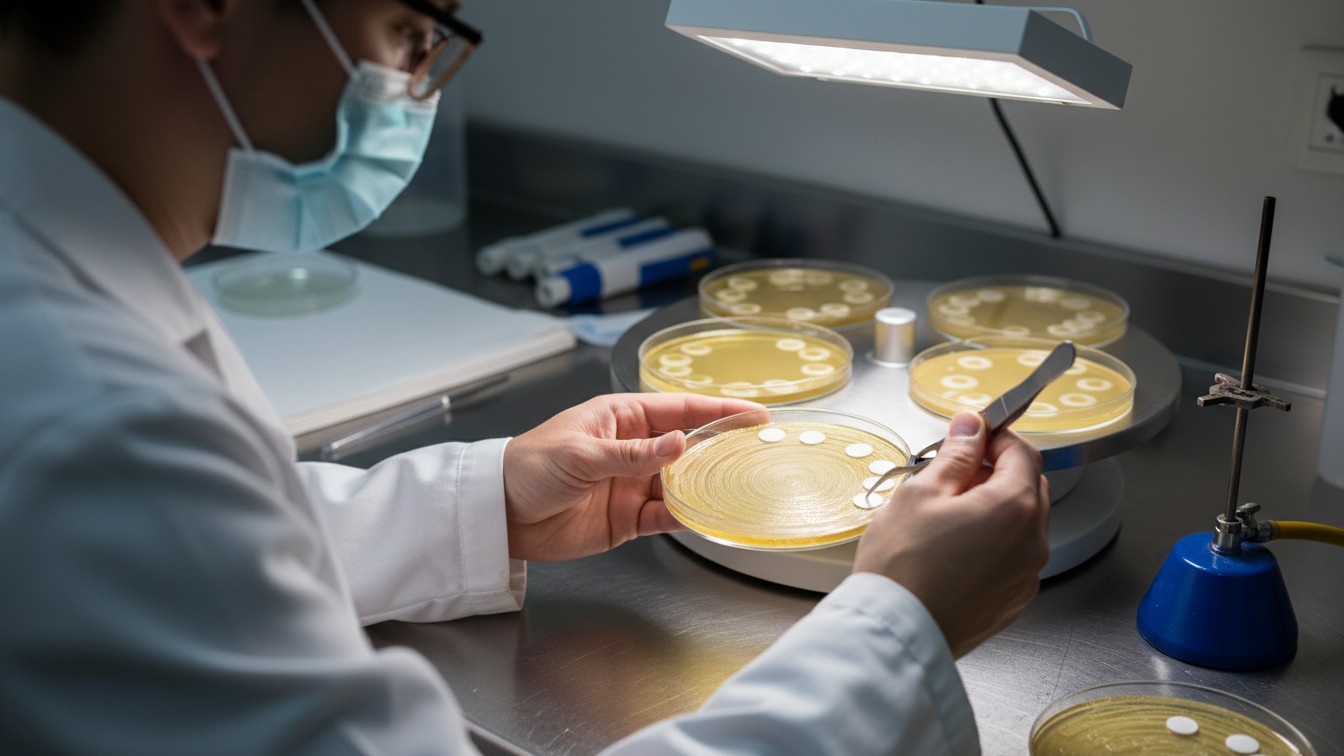
jamil nihal
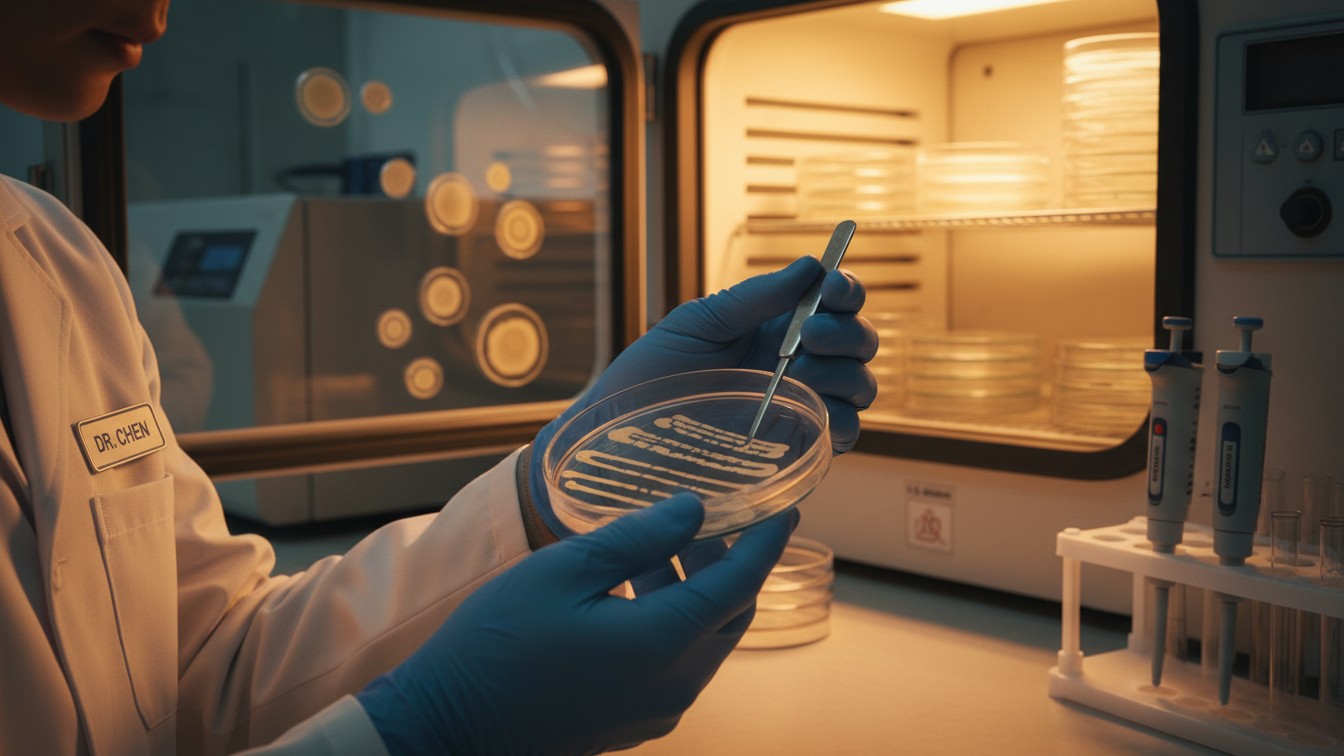
jamil nihal

Microbial Insights
Explore. Research. Reveal.
Discover a curated collection of microbiological studies, scientific insights, and laboratory work dedicated to understanding life beyond the visible.
This Weekend’s Projects
Microbial Guardians
Tag #EssentialBacteria supporting human health.

L. Acidophilus
Digestive Guardian

B. lactis
Immune Modulator

F. prausnitzii
Anti-Inflammatory

S. thermophilus
Fermentation Workhorse
From the Blog
Mycology Guide for Beginners
Introduction Mycology is the scientific study of fungi, encompassing yeasts, molds, mushrooms, and other related organisms that play essential roles
Read moreParasitology Complete Guide: Types, Life Cycles, Diseases & Treatment
Introduction Parasitology is the branch of biology that studies parasites, their structure, life cycles, the diseases they cause, and methods
Read moreMicrobial Genetics Complete Guide: Genome Structure, Gene Regulation, Mutations & Applications
Introduction to Microbial Genetics Microbial Genetics is a specialized branch of genetics that focuses on the genetic material of microorganisms,
Read moreInfluenza Virus Complete Guide: Types, Symptoms, Treatment & Prevention
What is the Influenza Virus? The influenza virus is an enveloped, segmented RNA virus that primarily affects the respiratory system
Read moreE. coli Infection: Causes, Symptoms, Treatment & Prevention
What is E. coli? E. coli (Escherichia coli) is a Gram-negative bacterium commonly found in the intestines of humans and
Read more
I’m M. Jamil
Result-oriented Microbiology Technologist with over 8 years of comprehensive experience in high-volume clinical diagnostic environments. Proven expertise in the end-to-end management of specimen processing and advanced microbiological analysis. Technical lead with a deep-seated commitment to laboratory excellence, specializing in the implementation of ISO 15189 and CLSI standards to ensure the highest levels of diagnostic accuracy and patient safety.
What drives me is actually patient health…
More about meJoin the Inner Circle
Get exclusive microbial insights, free lab resources, and weekly scientific inspiration delivered straight to your inbox. No spam, just discovery.